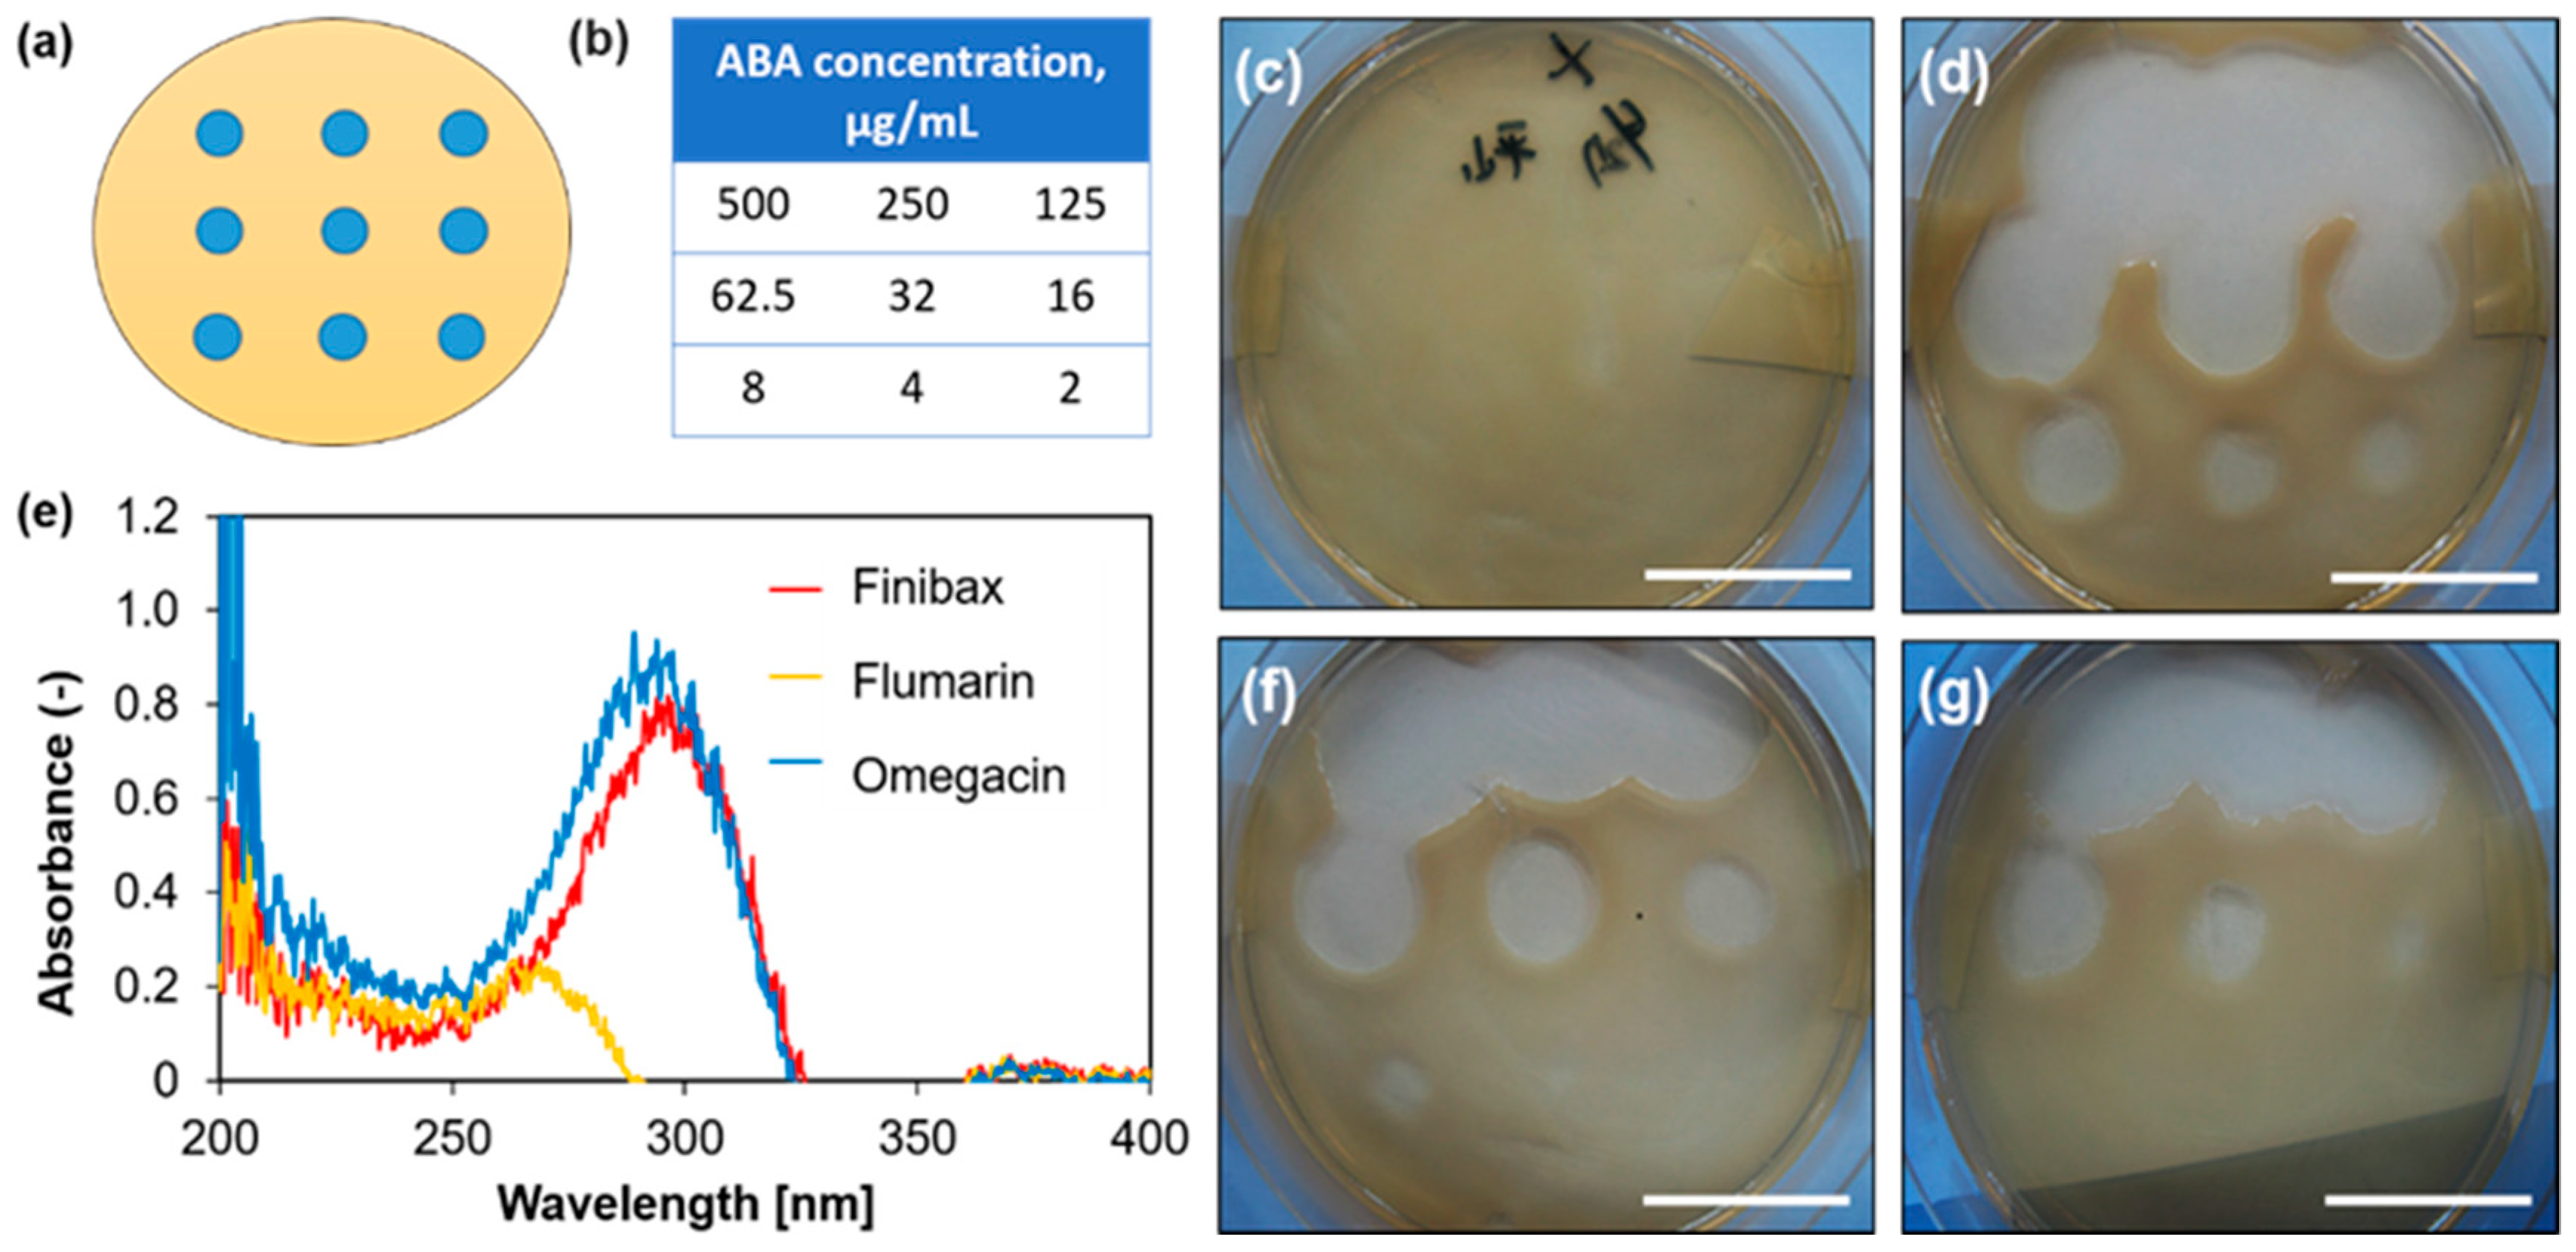

Antibacterial-Agent-Immobilized Gelatin Hydrogel as a 3D Scaffold for Natural and Bioengineered Tissues
Abstract
1. Introduction
2. Results and Discussion
2.1. Selection of an ABA
2.2. Immobilization of the ABA
2.3. Evaluation of the Antibacterial Activity of the ABA after Immobilization
2.4. Antibacterial Activity of the Gel
2.5. Evaluation of Cytotoxicity of the Gel Surface
3. Materials and Methods
3.1. Chemicals and Reagents
3.2. Selection of the Antibacterial Agent
3.2.1. Evaluation of Effective Concentration
3.2.2. Spectrum Measurement
3.3. Immobilization of the ABA
3.3.1. Evaluation Based on the Release of the ABA into the Liquid
3.3.2. Evaluation of the Immobilization amount by Gel Decomposition
3.3.3. Evaluation of the Crosslinking Potential with the EDC/NHS Couple
3.4. Evaluation of Antibacterial (AB) Activity of ABA after Immobilization
3.4.1. Correlation Evaluation of the E. coli and Turbidity
3.4.2. Correlation Evaluation of the ABA Concentration and Turbidity
3.4.3. E. coli Culture on the Gel
3.5. Antibacterial Activity of the Gel Surface
3.5.1. Observation of Double Zone Growth Inhibition
3.5.2. E. coli Culture on the Gel
3.5.3. Measurement of the Number of Bacteria in Rat Subcutaneous Implantation
3.5.4. E. coli Bacterial Density in Relation to the Turbidity Method.
3.6. Evaluation of the Cytotoxicity of the Gel
3.6.1. HUVEC Culture on the Gel
3.6.2. H&E Staining of the Gel after Subcutaneous Implantation in Rats
Author Contributions
Funding
Acknowledgments
Conflicts of Interest
References
- Nakamura, S.; Kubo, T.; Ijima, H. Heparin-conjugated gelatin as a growth factor immobilization scaffold. J. Biosci. Bioeng. 2013, 115, 562–567. [Google Scholar] [CrossRef] [PubMed]
- Drury, J.L.; Mooney, D.J. Hydrogels for tissue engineering: Scaffold design variables and applications. Biomaterials 2003, 24, 4337–4351. [Google Scholar] [CrossRef]
- Merion, R.M.; Ashby, V.B.; Wolfe, R.A.; Distant, D.A.; Hulbert-Shearon, T.E.; Metzger, R.A.; Ojo, A.O.; Port, F.K. Deceased-donor characteristics and the survival benefit of kidney transplantation. J. Am. Med. Assoc. 2005, 294, 2726–2733. [Google Scholar] [CrossRef] [PubMed]
- Van Vlierberghe, S.; Dubruel, P.; Schacht, E. Biopolymer-based hydrogels as scaffolds for tissue engineering applications: A review. Biomacromolecules 2011, 12, 1387–1408. [Google Scholar] [CrossRef] [PubMed]
- Ahmed, E.M. Hydrogel: Preparation, characterization, and applications: A review. J. Adv. Res. 2015, 6, 105–121. [Google Scholar] [CrossRef] [PubMed]
- Schwartz, D.A.; Petersen, B.T.; Poterucha, J.J.; Gostout, C.J. Endoscopic therapy of anastomotic bile duct strictures occurring after liver transplantation. Gastrointest. Endosc. 2000, 51, 169–174. [Google Scholar] [CrossRef]
- Ammori, B.J.; Joseph, S.; Attia, M.; Lodge, J.P.; Beger, H.G.; Schwarz, A. Biliary strictures complicating pancreaticoduodenectomy. Int. J. Pancreatol. 2000, 28, 15–22. [Google Scholar] [CrossRef]
- Tajeddin, E.; Sherafat, S.J.; Majidi, M.R.S.; Alebouyeh, M.; Alizadeh, A.H.M.; Zali, M.R. Association of diverse bacterial communities in human bile samples with biliary tract disorders: A survey using culture and polymerase chain reaction-denaturing gradient gel electrophoresis methods. Eur. J. Clin. Microbiol. Infect. Dis. 2016, 35, 1331–1339. [Google Scholar] [CrossRef]
- Walsh, F. Doripenem: A new carbapenem antibiotic a review of comparative antimicrobial and bactericidal activities. Ther. Clin. Risk Manag. 2007, 3, 789–794. [Google Scholar] [PubMed]
- Shanmugasundaram, T.; Radhakrishnan, M.; Gopikrishnan, V.; Kadirvelu, K.; Balagurunathan, R. In vitro antimicrobial and in vivo wound healing effect of actinobacterially synthesised nanoparticles of silver, gold and their alloy. RSC Adv. 2017, 7, 51729–51743. [Google Scholar] [CrossRef]
- Queenan, A.M.; Bush, K. Carbapenemases: The Versatile β-Lactamases. Clin. Microbiol. Rev. 2007, 20, 440–458. [Google Scholar] [CrossRef] [PubMed]
- Park, H.; Park, K. Hydrogels in Bioapplications; American Chemical Society: Washington, DC, USA, 1996; Chapter 1; pp. 2–10. [Google Scholar] [CrossRef]
- Zhanel, G.G.; Wiebe, R.; Dilay, L.; Thomson, K.; Rubinstein, E.; Hoban, D.J.; Noreddin, A.M.; Karlowsky, J.A. Comparative review of the carbapenems-Focus on doripenem. Drugs 2007, 67, 1027–1052. [Google Scholar] [CrossRef] [PubMed]
- Susan, J.K. Doripehem: A review of its use in the treatment of bacterial infections. Drugs 2008, 68, 2021–2067. [Google Scholar]
- Ullah, H.; Ali, S. Classification of Anti-Bacterial Agents and Their Functions. Antibact. Agents. 2017. [Google Scholar] [CrossRef]
- Hoare, T.R.; Kohane, D.S. Hydrogels in drug delivery: Progress and challenges. Polymer 2008, 49, 1993–2007. [Google Scholar] [CrossRef]
- Preparation, A. Polyvinyl Alcohol–Gelatin Patches of Salicylic Acid: Preparation, Characterization and Drug Release Studies. J. Biomater. Appl. 2006. [Google Scholar] [CrossRef]
- Burkert, S.; Schmidt, T.; Gohs, U.; Dorschner, H.; Arndt, K.F. Cross-linking of poly (N-vinyl pyrrolidone) films by electron beam irradiation. Radiat. Phys. Chem. 2007, 76, 1324–1328. [Google Scholar] [CrossRef]
- Gulrez, S.K.H.; Al-Assaf, S.; Phillips, G.O. Hydrogels: Methods of Preparation, Characterisation and Applications. In Progress in Molecular and Environmental Bioengineering: From Analysis and Modeling to Technology Applications; Carpi, A., Ed.; Books on Demand: Wrexham, UK, 2011. [Google Scholar] [CrossRef]
- Conde, J.; Dias, J.T.; Grazu, V.; Moros, M.; Baptista, P.V.; de la Fuente, J.M. Revisiting 30 years of biofunctionalization and surface chemistry of inorganic nanoparticles for nanomedicine. Front. Chem. 2014, 2, 1–27. [Google Scholar] [CrossRef]
- Sanz, V.; Conde, J.; Hernández, Y.; Baptista, P.V.; Ibarra, M.R.; de la Fuente, J.M. Effect of PEG biofunctional spacers and TAT peptide on dsRNA loading on gold nanoparticles. J. Nanopart. Res. 2012. [Google Scholar] [CrossRef]
- Microbial Growth. Prescott’s Microbiology, 9th Edition. Available online: https://studylib.net/search/?q=microbial+growth (accessed on 10 February 2019).
- Egawa, H.; Inomata, Y.; Uemoto, S.; Asonuma, K.; Kiuchi, T.; Fujita, S.; Hayashi, M.; Matamoros, M.A.; Itou, K.; Tanaka, K. Biliary anastomotic complications in 400 living related liver transplantations. World J. Surg. 2001, 25, 1300–1307. [Google Scholar] [CrossRef]
- Hu, B.; Owh, C.; Chee, P.L.; Leow, W.R.; Liu, X.; Wu, Y.L.; Guo, P.; Loh, X.J.; Chen, X. Supramolecular hydrogels for antimicrobial therapy. Chem. Soc. Rev. 2018, 47, 6917–6929. [Google Scholar] [CrossRef] [PubMed]

| FDA *-Approved ABA | Trade Name | Category | Approval Year/Trial Year |
|---|---|---|---|
| Finibax | Doripenem | β-Lactam-carbapenem | 2007 |
| Flomoxef | Flumarin | β-Lactam-cephalosporins | 1988 |
| Biapenem | Omegacin | β-Lactam-carbapenem | 2002 |
| Case No. | Concentration, mg/mL | |
|---|---|---|
| EDC | NHS | |
| 1 | 0 | 0 |
| 2 | 10 | 6 |
| 3 | 20 | 12 |
| 4 | 40 | 24 |
| Condition Name | Composition |
|---|---|
| ABA-free | Collagenase solution mixed with E. coli liquid |
| Non-immobilized ABA | ABA solution (solvent: collagenase solution) mixed with E. coli liquid |
| Immobilized ABA | ABA-immobilized gel mixed with E. coli liquid |
© 2019 by the authors. Licensee MDPI, Basel, Switzerland. This article is an open access article distributed under the terms and conditions of the Creative Commons Attribution (CC BY) license (http://creativecommons.org/licenses/by/4.0/).
Share and Cite
Iimaa, T.; Hirayama, T.; Shirakigawa, N.; Imai, D.; Yamao, T.; Yamashita, Y.-i.; Baba, H.; Ijima, H. Antibacterial-Agent-Immobilized Gelatin Hydrogel as a 3D Scaffold for Natural and Bioengineered Tissues. Gels 2019, 5, 32. https://doi.org/10.3390/gels5020032
Iimaa T, Hirayama T, Shirakigawa N, Imai D, Yamao T, Yamashita Y-i, Baba H, Ijima H. Antibacterial-Agent-Immobilized Gelatin Hydrogel as a 3D Scaffold for Natural and Bioengineered Tissues. Gels. 2019; 5(2):32. https://doi.org/10.3390/gels5020032
Chicago/Turabian StyleIimaa, Tuyajargal, Takaaki Hirayama, Nana Shirakigawa, Daisuke Imai, Takanobu Yamao, Yo-ichi Yamashita, Hideo Baba, and Hiroyuki Ijima. 2019. "Antibacterial-Agent-Immobilized Gelatin Hydrogel as a 3D Scaffold for Natural and Bioengineered Tissues" Gels 5, no. 2: 32. https://doi.org/10.3390/gels5020032
APA StyleIimaa, T., Hirayama, T., Shirakigawa, N., Imai, D., Yamao, T., Yamashita, Y.-i., Baba, H., & Ijima, H. (2019). Antibacterial-Agent-Immobilized Gelatin Hydrogel as a 3D Scaffold for Natural and Bioengineered Tissues. Gels, 5(2), 32. https://doi.org/10.3390/gels5020032

